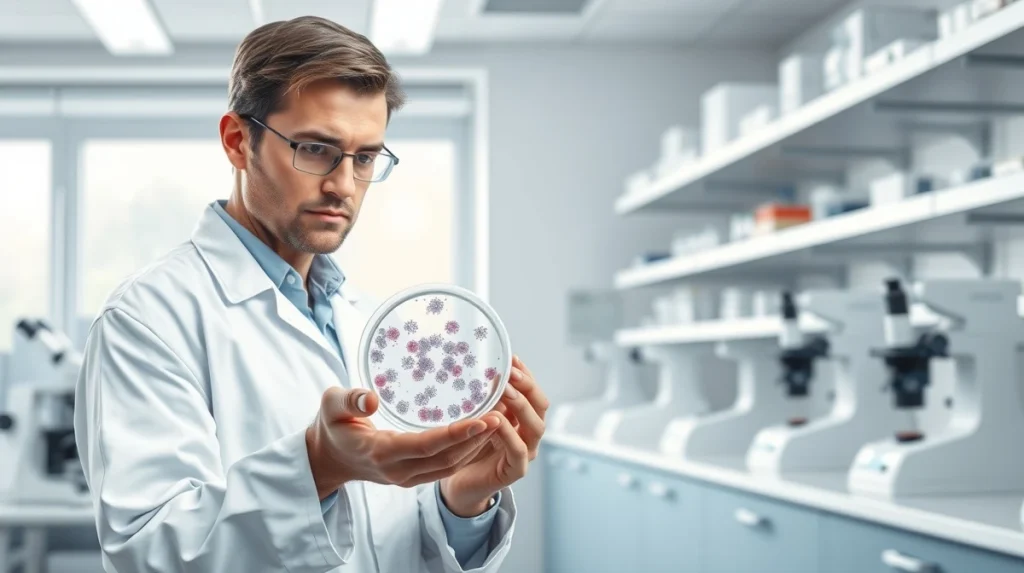

Graft Versus Host Disease Clinical Trial Pipeline Shows Promising Momentum as 45+ Pharma Companies Advance Research
The clinical trial pipeline for graft versus host disease (GVHD) demonstrates significant research activity as more than 45 pharmaceutical companies actively develop treatments for this serious transplant complication. This solid pipeline represents a major advancement in hematology and immunology research, offering potential new options for patients undergoing hematopoietic stem cell transplantation. Current developments focus on novel immunotherapies and targeted approaches that could transform standard care protocols.
Understanding Graft Versus Host Disease and Current Treatment Challenges
Graft versus host disease represents a serious complication following hematopoietic stem cell transplantation. This condition occurs when donor immune cells attack the recipient’s healthy tissues. Consequently, patients experience symptoms ranging from skin rashes to life-threatening organ damage. Currently, standard treatments include corticosteroids and immunosuppressive medications. However, these approaches often prove insufficient for many patients. Therefore, the medical community urgently needs more effective therapeutic options.
Also read: SpaceX IPO Is Not Draining Crypto Liquidity, Bitunix Analyst Argues
The GVHD treatment market has evolved significantly in recent years. Research now focuses on more targeted approaches that modulate specific immune pathways. Additionally, researchers aim to preserve the beneficial graft-versus-leukemia effect while minimizing harmful immune responses. This delicate balance represents a central challenge in transplantation medicine. Pharmaceutical companies have responded by increasing their research investments substantially.
Analysis of the Current GVHD Clinical Trial Pipeline
The GVHD clinical trial pipeline includes diverse therapeutic approaches across multiple development stages. Companies are investigating small molecules, monoclonal antibodies, and cellular therapies. Furthermore, many candidates target specific immune pathways involved in GVHD pathogenesis. This targeted approach represents a shift from broad immunosuppression to precision medicine.
Also read: Official Trump Price Stages a Recovery: Bullish Reversal or Bear Market Bounce?
Pipeline Composition and Development Stages
The pipeline contains candidates in various development phases:
- Phase III trials: Several therapies have reached late-stage testing with promising preliminary results
- Phase II trials: Multiple candidates demonstrate efficacy in mid-stage studies
- Phase I trials: Early-stage investigations explore safety profiles of novel mechanisms
- Preclinical research: Numerous compounds show potential in laboratory models
Research focuses particularly on acute and chronic GVHD forms. Acute GVHD typically occurs within 100 days post-transplantation. Chronic GVHD develops later and often resembles autoimmune disorders. Pharmaceutical companies recognize these distinct presentations require different therapeutic strategies. Consequently, many pipeline candidates target specific disease subtypes.
Key Therapeutic Approaches in GVHD Development
Several innovative approaches dominate the current GVHD research market. First, JAK inhibitors have shown significant promise in clinical trials. These medications modulate cytokine signaling pathways central to GVHD development. Second, researchers are investigating selective T-cell modulation strategies. These approaches aim to control harmful immune responses while preserving beneficial immunity.
Third, cellular therapies represent another promising avenue. Mesenchymal stromal cells demonstrate immunomodulatory properties that may benefit GVHD patients. Fourth, antibody-based therapies target specific immune checkpoints and inflammatory mediators. Finally, combination approaches seek to enhance efficacy through synergistic mechanisms. This diversity of approaches increases the likelihood of successful treatment options reaching patients.
Mechanism of Action Comparison
| Therapeutic Class | Primary Mechanism | Development Stage |
|---|---|---|
| JAK Inhibitors | Blocks cytokine signaling pathways | Phase II/III |
| Monoclonal Antibodies | Targets specific immune cells/proteins | Phase I-III |
| Cellular Therapies | Modulates immune response via living cells | Phase II/III |
| Small Molecules | Inhibits intracellular signaling pathways | Phase I-II |
Research Trends and Future Directions
The GVHD research field shows several important trends. First, biomarker development receives increased attention. Researchers seek predictive markers to identify high-risk patients earlier. Second, personalized treatment approaches gain traction. These strategies tailor therapies based on individual patient characteristics. Third, combination therapies represent a growing research area. Scientists investigate how different mechanisms might work together synergistically.
Additionally, real-world evidence studies complement traditional clinical trials. These investigations provide insights into long-term outcomes and real-world effectiveness. Furthermore, patient-reported outcomes receive greater emphasis in trial design. This shift recognizes the importance of quality-of-life measures alongside traditional efficacy endpoints. Finally, global collaboration increases as researchers share data across institutions and countries.
Clinical Implications and Patient Impact
The expanding GVHD pipeline carries significant implications for clinical practice. First, new treatment options could improve survival rates for transplant recipients. Second, novel therapies may reduce treatment-related toxicities compared to current standards. Third, targeted approaches might enable more precise management of immune responses. Fourth, combination strategies could address the complex pathophysiology more comprehensively.
Patients stand to benefit from several pipeline advancements. Reduced steroid dependence represents a key potential advantage. Many current treatments require high-dose corticosteroids with substantial side effects. Novel therapies might achieve similar efficacy with fewer adverse events. Additionally, prevention strategies could reduce GVHD incidence altogether. Some pipeline candidates focus specifically on prophylactic approaches.
Conclusion
The graft versus host disease clinical trial pipeline demonstrates sturdy activity with substantial pharmaceutical investment. More than 45 companies actively develop treatments across multiple therapeutic classes and mechanisms. This diverse research sector offers hope for improved outcomes following hematopoietic stem cell transplantation. Continued progress depends on successful clinical trial completion and regulatory approval. The medical community anticipates several potential approvals in coming years based on current pipeline momentum.
FAQs
Q1: What is graft versus host disease?
Graft versus host disease is a serious complication where donor immune cells attack the recipient’s body after stem cell or bone marrow transplantation. The condition can affect multiple organs and ranges from mild to life-threatening.
Q2: Why are so many companies developing GVHD treatments?
The significant unmet medical need drives pharmaceutical investment. Current treatments have limitations, and improved therapies could benefit thousands of transplant patients annually. The complex disease biology also allows for multiple therapeutic approaches.
Q3: What types of treatments are in development?
The pipeline includes JAK inhibitors, monoclonal antibodies, cellular therapies, and small molecules. These approaches target different aspects of the immune response that causes GVHD.
Q4: How long until new GVHD treatments reach patients?
Several candidates are in late-stage clinical trials, suggesting potential approvals within the next few years. However, exact timelines depend on trial results and regulatory review processes.
Q5: How will new treatments improve upon current options?
Novel therapies aim to provide better efficacy with fewer side effects than current steroid-based regimens. Targeted approaches may also allow more precise control of immune responses while preserving beneficial graft effects.
